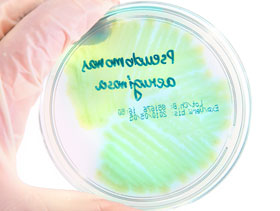

De Frente al Campo TV Online Federal

El equipo de investigación de Stefanie Bruckner, Antonia Albrecht, Brigitte Petersen y Judith Kreyenschmidt de la Universidad de Bonn y de la Universidad de Ciencias Aplicadas de Münster examinó el crecimiento de Pseudomonas spp., según las fluctuaciones de la cadena de frío en productos frescos de cerdo y ave.
A través de este estudio pudieron establecer la vida útil del producto.
En cada ensayo, la vida útil en la situación de control de 4°C (constante) se comparó con la vida útil en dos situaciones dinámicas que incluyeron cambios de temperatura de 4° a 7° y a 15°, respectivamente.
En general, la carne fresca de cerdo y la de ave mostraron patrones de desperdicio similares en las condiciones térmicas dinámicas con reducciones significativas de la vida útil cuando se producían subidas cortas de temperatura al principio del almacenamiento.
La reducción de la vida útil fue de hasta dos días o más del 30%, aunque el tiempo de almacenamiento con una temperatura abusiva fue menor al 5% del tiempo total de almacenamiento.
Factores intrínsecos
En otro estudio, a pesar del factor extrínseco, la temperatura, se analizaron los factores intrínsecos: valor de pH, valor AW, la fuerza de cizalla Warner-Bratzler (del inglés, WBSF), D-glucosa, ácido L-láctico, contenido graso y contenido proteíco.
El equipo averiguó que el crecimiento de Pseudomonas spp., era claramente dependiente de la temperatura, con un crecimiento más rápido si había temperaturas más altas.
El equipo de investigación dijo que el crecimiento fue más rápido en la carne de ave fresca que en la de cerdo lo que dio como resultado vidas útiles más cortas a temperaturas constantes entre 2º y 15ºC. Casi todos los factores intrínsecos analizados fueron muy diferentes (P<0,05) para la carne fresca de cerdo y ave (excepto el valor AW y el ácido L-láctico).
Como se esperaba, las situaciones con cambios a 15°C llevaron a reducciones de vida útil más altas que aquellas con cambios a 7°C en ambos tipos de carne.
El equipo de investigación dijo que el desperdicio prematuro de carne fresca conduce al desperdicio alimentario y, por lo tanto, a pérdidas económicas así como a una pérdida de confianza por parte del consumidor.
Pseudomonas
Hasta ahora, no había estudios detallados que describieran y compararan los distintos parámetros intrínsecos y extrínsecos así como su influencia en el crecimiento de Pseudomonas spp., como un organismo específico que lleva al desecho de la carne en diferentes tipos de carne.
El entendimiento de los factores que repercuten en la vida útil de la carne fresca de cerdo y pollo es un requisito previo para el desarrollo de métodos y herramientas que mejoren el procesamiento en las cadenas de suministro cárnico.
En concreto, los resultados pueden servir como cimientos para el desarrollo de modelos matemáticos que puedan predecir la vida útil y el tiempo que queda de vida útil en ambos tipos de carne.
Estos estudios se publicaron en el International Journal of Food Science and Technology y el Journal of Food Quality.